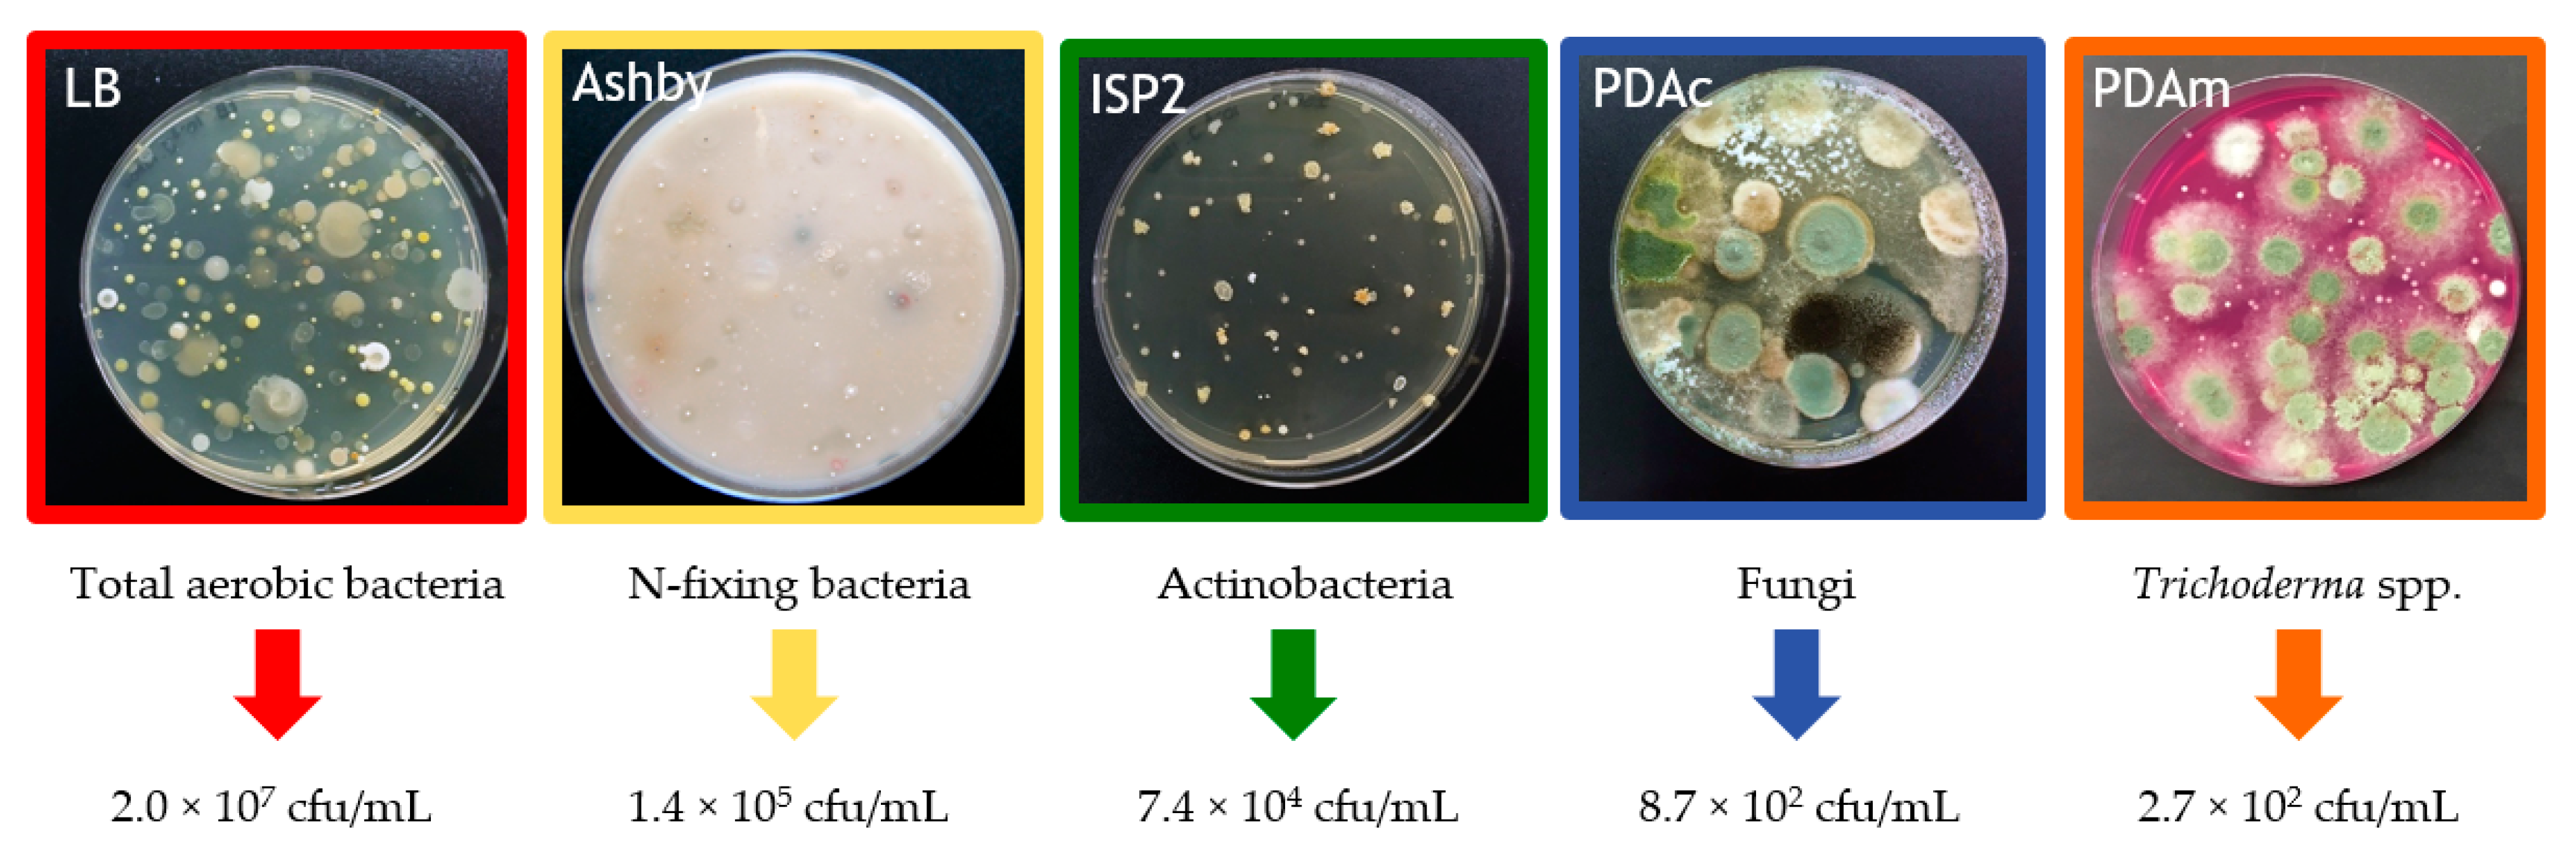
Agronomy 11 00781 g002

Compost Tea Induces Growth and Resistance against Rhizoctonia solani and Phytophthora capsici in Pepper
Abstract
:1. Introduction
2. Materials and Methods
2.1. Compost Tea Preparation
2.2. Chemical and Microbiological Properties of the Compost Tea
2.3. In Vitro Assays
2.4. In Vivo Assays
2.5. Statistical Analyses
3. Results
3.1. Compost Tea Properties
3.2. Compost Tea Effect in In Vitro Assays against Rhizoctonia solani and Phytophthora capsici
3.3. Compost Tea Effect in In Vivo Assays against Rhizoctonia solani and Phytophthora capsici
4. Discussion
5. Conclusions
Author Contributions
Funding
Institutional Review Board Statement
Acknowledgments
Conflicts of Interest
References
- Zaller, J.G. Vermicompost as a substitute for peat in potting media: Effects on germination, biomass allocation, yields and fruit quality of three tomato varieties. Sci. Hortic. 2007, 112, 191–199. [Google Scholar] [CrossRef]
- Bernal, M.P.; Alburquerque, J.A.; Moral, R. Composting of animal manures and chemical criteria for compost maturity assessment. A review. Bioresour. Technol. 2009, 100, 5444–5453. [Google Scholar] [CrossRef]
- Benito, M.; Masaguer, A.; De Antonio, R.; Moliner, A. Use of pruning waste compost as a component in soilless growing media. Bioresour. Technol. 2005, 96, 597–603. [Google Scholar] [CrossRef]
- Darzi, M.T.; Seyedhadi, M.H.; Rejali, F. Effects of the application of vermicompost and phosphate solubilizing bacterium on the morphological traits and seed yield of anise (Pimpinella anisum L.). J. Med. Plants Res. 2012, 6, 215–219. [Google Scholar]
- Moretti, S.M.L.; Bertoncini, I.B.; Abreu-Junior, C.H. Composting sewage sludge with green waste from tree pruning. Sci. Agric. 2015, 72, 432–439. [Google Scholar] [CrossRef]
- Marin, F.; Santos, M.; Dianez, F.; Carretero, F.; Gea, F.J.; Yau, J.A.; Navarro, M.J. Characters of compost teas from different sources and their suppressive effect on fungal phytopathogens. World J. Microbiol. Biotechnol. 2013, 29, 1371–1381. [Google Scholar] [CrossRef] [PubMed]
- Markakis, E.A.; Fountoulakis, M.S.; Daskalakis, G.C.; Kokkinis, M.; Ligoxigakis, E.K. The suppressive effect of compost amendments on Fusarium oxysporum f.sp. radicis-cucumerinum in cucumber and Verticillium dahliae in eggplant. Crop Prot. 2016, 79, 70–79. [Google Scholar] [CrossRef]
- Al-Dahmani, J.H.; Abbasi, P.A.; Miller, S.A.; Hoitink, H.A.J. Suppression of bacterial spot of tomato with foliar sprays of compost extracts under greenhouse and field conditions. Plant Dis. 2003, 87, 913–919. [Google Scholar] [CrossRef] [PubMed] [Green Version]
- Morales-Corts, M.R.; Pérez-Sánchez, R.; Gómez-Sánchez, M.A. Efficiency of garden waste compost teas on tomato growth and its suppressiveness against soilborne pathogens. Sci. Agric. 2018, 75, 400–409. [Google Scholar] [CrossRef]
- Ingham, E.R. What is compost tea? Part 1. BioCycle 1999, 40, 74–75. [Google Scholar]
- Martin, C.C.G.; Dorinvil, W.; Brathwaite, R.A.I.; Ramsubhag, A. Effects and relationships of compost type, aeration and brewing time on compost tea properties, efficacy against Pythium ultimum, phytotoxicity and potential as a nutrient amendment for seedling production. Biol. Agric. Hortic. 2012, 28, 185–205. [Google Scholar] [CrossRef] [Green Version]
- Mengesha, W.K.; Powel, S.M.; Evans, K.J.; Barry, K.M. Diverse microbial communities in non-aerated compost teas suppress bacterial wilt. World J. Microbiol. Biotechnol. 2017, 33, 49. [Google Scholar] [CrossRef]
- De Corato, U. Agricultural waste recycling in horticultural intensive farming systems by on-farm composting and compost-based tea application improves soil quality and plant health: A review under the perspective of a circular economy. Sci Total Environ. 2020, 738, 139840. [Google Scholar] [CrossRef] [PubMed]
- Zaccardelli, M.; Sorrentino, R.; Caputo, M.; Scotti, R.; De Falco, E.; Pane, C. Stepwise-Selected Bacillus amyloliquefaciens and B. subtilis Strains from Composted Aromatic Plant Waste Able to Control Soil-Borne Diseases. Agriculture 2020, 10, 30. [Google Scholar] [CrossRef] [Green Version]
- Castano, R.; Borrero, C.; Aviles, M. Organic matter fractions by SP-MAS 13C NMR and microbial communities involved in the suppression of Fusarium wilt in organic growth media. Biol. Control 2011, 58, 286–293. [Google Scholar] [CrossRef]
- Siddiqui, Y.; Sariah, M.; Ismail, M.R.; Asgar, A. Trichoderma-fortified compost extracts for the control of Choanephora wet rot in okra production. Crop Prot. 2008, 27, 385–390. [Google Scholar] [CrossRef]
- Pant, A.P.; Radovich, T.J.; Hue, N.V.; Paull, R.E. Biochemical properties of compost tea associated with compost quality and effects on pak choi growth. Sci. Hortic. 2012, 148, 138–146. [Google Scholar] [CrossRef]
- Ilangumaran, G.; Smith, D.L. Plant growth promoting rhizobacteria in amelioration of salinity stress: A systems biology perspective. Front. Plant Sci. 2017, 8, 1768. [Google Scholar] [CrossRef]
- Hamid, S.; Ahmad, I.; Akhtar, M.J.; Iqbal, M.N.; Shakir, M.; Tahir, M.; Rasool, A.; Sattar, A.; Khalid, M.; Ditta, A.; et al. Bacillus subtilis Y16 and biogas slurry enhanced potassium to sodium ratio and physiology of sunflower (Helianthus annuus L.) to mitigate salt stress. Environ. Sci. Pollut Res. Int. 2021. Online ahead of print. [Google Scholar] [CrossRef]
- Martin, C.C.S. Potential of compost tea for suppressing plant diseases. CAB Rev. 2014, 9, 1–38. [Google Scholar]
- Pane, C.; Celano, G.; Villecco, D.; Zaccardelli, M. Control of Botrytis cinerea, Alternaria alternata and Pyrenochaeta lycopersici on tomato with whey compost-tea applications. Crop Prot. 2012, 38, 80–86. [Google Scholar] [CrossRef]
- Shaban, H.; Fazeli-Nasab, B. An Overview of the Benefits of Compost tea on Plant and Soil Structure. Adv. Biores. 2015, 6, 154–158. [Google Scholar]
- Food and Agriculture Organization (FAO). Faostat: Agriculture Data. 2019. Available online: http://www.fao.org/faostat/en/#data/QC/visualize (accessed on 5 December 2020).
- Sundaramoorthy, S.; Raguchander, T.; Ragupathi, N.; Samiyappan, R. Combinatorial effect of endophytic and plant growth promoting rhizobacteria against wilt disease of Capsicum annuum L. caused by Fusarium Solani. Biol. Control 2012, 60, 59–67. [Google Scholar]
- Kim, E.H.; Lee, S.Y.; Baek, D.Y.; Park, S.Y.; Lee, S.G.; Ryu, T.H.; Lee, S.K.; Kang, H.J.; Kwon, O.H.; Kil, M.; et al. A comparison of the nutrient composition and statistical profile in red pepper fruits (Capsicums annuum L.) based on genetic and environmental factors. Appl. Biol. Chem. 2019, 62, 48. [Google Scholar] [CrossRef] [Green Version]
- Barchenger, D.W.; Lamour, K.H.; Bosland, P.W. Challenges and Strategies for Breeding Resistance in Capsicum annuum to the Multifarious Pathogen, Phytophthora Capsici. Front Plant Sci. 2018, 9, 628. [Google Scholar] [CrossRef]
- Sherf, A.F.; MacNab, A.A. Vegetable Diseases and Their Control, 2nd ed.; Wiley: New York, NY, USA, 1986; pp. 334–337. [Google Scholar]
- Mannai, S.; Jabnoun-Khiareddine, H.; Nasraoui, B.; Daami-Remadi, M. Rhizoctonia Root Rot of Pepper (Capsicum annuum): Comparative Pathogenicity of Causal Agent and Biocontrol Attempt using Fungal and Bacterial Agents. J. Plant Pathol. Microbiol. 2018, 9, 1000431. [Google Scholar]
- Morales-Corts, M.R.; Gómez-Sánchez, M.A.; Pérez-Sánchez, R. Evaluation of green/pruning wastes compost and vermicompost, slumgum compost and their mixes as growing media for horticultural production. Sci. Hortic. 2014, 172, 155–160. [Google Scholar] [CrossRef]
- Wickerham, L.J. Taxonomy of yeasts. U.S. Dept. Agric. Tech. Bull. 1951, 1029, 1–56. [Google Scholar]
- Sanchis Solera, J. Comparación entre los diversos medios de cultivo comerciales para aislamiento de hongos (levaduras y mohos). In Proyecto Microkit 1999 Para Optimizar la Sensibilidad de los Parámetros de Muestras Microbiológicos del aire; Laboratorios Microkit, S.L.: Madrid, Spain, 1996. [Google Scholar]
- Stella, M.; Suhaimi, M. Selection of suitable growth medium for free-living diazotrophs isolated from compost. J. Trop. Agric. Fd. Sc. 2010, 38, 211–219. [Google Scholar]
- Vargas-Gil, S.; Pastor, S.; March, G.J. Quantitative isolation of biocontrol agents Trichoderma spp., Gliocladium spp. and actinomycetes from soil with culture media. Microbiol. Res. 2006, 164, 196–205. [Google Scholar] [CrossRef]
- Köller, W.; Wilcox, W.F. Evidence for the predisposition of fungicide-resistant isolates of venturia inaequalis to a preferential selection for resistance to other fungicides. Phytopathology 2001, 91, 776–781. [Google Scholar] [CrossRef] [PubMed] [Green Version]
- Holmes, K.A.; Benson, D.M. Evaluation of Phytophthora parasitica var. nicotianae for biocontrol of Phytophthora parasitica on Cathar. Roseus. Plant Dis. 1994, 78, 193–199. [Google Scholar] [CrossRef]
- Scheuerell, S.J.; Mahaffee, W.F. Compost tea as a container medium drench for suppressing seedling damping-off caused by Pythium ultimum. Phytopathology 2004, 94, 1156–1163. [Google Scholar] [CrossRef] [Green Version]
- Siddiqui, Y.; Meon, S.; Ismai, R.; Rahmani, M. Bio-potential of compost tea from agro-waste to suppress Choanephora cucurbitarum L. the causal pathogen of wet rot of okra. Biol. Control 2009, 49, 38–44. [Google Scholar] [CrossRef]
- Naidu, Y.; Meon, S.; Kadir, J.; Siddiqui, Y. Microbial starter for the enhancement of biological activity of compost tea. Int. J. Agric Biol. 2010, 12, 51–56. [Google Scholar]
- Amtmann, A.; Troufflard, S.; Armengaud, P. The effect of potassium nutrition on pest and disease resistance in plants. Physiol. Plant. 2008, 133, 682–691. [Google Scholar] [CrossRef]
- Gholami, H.; Saharkhiz, M.J.; Fard, F.R.; Ghani, A.; Nadaf, F. Humic acid and vermicompost increased bioactive components, antioxidant activity and herb yield of Chicory (Cichorium intybus L.). Biocatal. Agric. Biotechnol. 2018, 14, 286–292. [Google Scholar] [CrossRef]
- Eyheraguibel, B.; Silvestre, J.; Morard, P. Effects of humic substances derived from organic waste enhancement on the growth and mineral nutrition of maize. Bioresour Technol. 2008, 99, 4206–4212. [Google Scholar] [CrossRef] [Green Version]
- Muscolo, A.; Sidari, M. Carboxyl and phenolic humic fractions affect callus growth and metabolism. Soil Sci. Soc. Am. J. 2009, 73, 1119–1129. [Google Scholar] [CrossRef]
- Kim, M.J.; Shim, C.K.; Kim, Y.K.; Hong, S.J.; Park, J.H.; Han, E.J.; Kim, J.H.; Kim, S.C. Effect of Aerated Compost Tea on the Growth Promotion of Lettuce, Soybean, and Sweet Corn in Organic Cultivation. Plant Pathol. J. 2015, 31, 259–268. [Google Scholar] [CrossRef] [Green Version]
- Li, X.; Wang, X.; Shi, X.; Wang, Q.; Li, X.; Zhang, S. Compost tea-mediated induction of resistance in biocontrol of strawberry Verticillium wilt. J. Plant Dis. Prot. 2020, 127, 257–268. [Google Scholar] [CrossRef]
- Dionne, A.; Tweddell, R.J.; Antoun, H.; Avis, T.J. Effect of non-aerated compost teas on damping-off pathogens of tomato. Can. J. Plant Pathol. 2012, 34, 51–57. [Google Scholar] [CrossRef]
- Diánez, F.; Santos, M.; Tello, J.C. Suppressive effects of grape marc compost on phytopathogenic oomycetes. Arch. Phytopathol. Plant Prot. 2007, 40, 1–18. [Google Scholar] [CrossRef]
- Phae, C.G.; Shoda, M. Expression of the suppresive effects of Bacillus sibtilis on phytopathogens in inoculated compost. J. Ferment Bioeng 1990, 70, 409–414. [Google Scholar] [CrossRef]
- Scheuerell, S.J.; Mahaffee, W.F. Compost Tea: Principles and Prospects for Plant Disease Control. Compost. Sci. Util. 2002, 10, 313–338. [Google Scholar] [CrossRef]
- Sylvia, E.W. The effect of compost extract on the yield of strawberries and severity of Botrytis Cinerea. J. Sustain Agr. 2004, 25, 57–68. [Google Scholar]
- Ingham, E.R. The Compost Tea Brewing Manual, 5th ed.; Soil Food International Inc.: Corvallis, OR, USA, 2005. [Google Scholar]
- Ros, M.; Hurtado-Navarro, M.; Giménez, A.; Fernández, J.A.; Egea-Gilabert, C.; Lozano-Pastor, P.; Pascual, J.A. Spraying Agro-Industrial Compost Tea on Baby Spinach Crops: Evaluation of Yield, Plant Quality and Soil Health in Field Experiments. Agronomy 2020, 10, 440. [Google Scholar] [CrossRef] [Green Version]
- Marín, F.; Diánez, F.; Santos, M.; Carretero, F.; Gea, F.J.; Castañeda, C.; Navarro, M.J.; Yau, J.A. Control of Phytophthora capsici and Phytophthora parasitica on pepper (Capsicum annuum L.) with compost teas form different sources, and their effects on plant growth promotion. Phytopathol. Mediterr. 2014, 53, 216–228. [Google Scholar]
- Reeve, J.R.; Carpenter-Boggs, L.; Reganold, J.P.; York, A.L.; Brinton, W.F. Influence of biodynamic preparations on compost development and resultant compost extracts on wheat seedling growth. Bioresour. Technol. 2010, 101, 5658–5666. [Google Scholar] [CrossRef]
- Ditta, A.; Imtiaz, M.; Mehmood, S.; Rizwan, M.S.; Mubeen, F.; Aziz, O.; Qian, Z.; Ijaz, R.; Tu, S. Rock phosphate enriched organic fertilizer with phosphate solubilizing microorganisms improves nodulation, growth and yield of legumes. Comm. Soil Sci. Plant Anal 2018, 49, 2715–2725. [Google Scholar] [CrossRef]
- Ditta, A.; Muhammad, J.; Imtiaz, M.; Mehmood, S.; Qian, Z.; Tu, S. Application of rock phosphate enriched composts increases nodulation, growth and yield of chickpea. Int. J. Recycl. Org. Waste Agric. 2018, 7, 33–40. [Google Scholar] [CrossRef] [Green Version]
- Hussain, A.; Zahir, Z.A.; Ditta, A.; Tahir, M.U.; Ahmad, M.; Mumtaz, M.Z.; Hayat, K.; Hussain, S. Production and Implication of Bio-Activated Organic Fertilizer Enriched with Zinc-Solubilizing Bacteria to Boost up Maize (Zea mays L.) Production and Biofortification under Two Cropping Seasons. Agronomy 2020, 10, 39. [Google Scholar] [CrossRef] [Green Version]
- López-Martín, J.J.; Morales-Corts, M.R.; Pérez-Sánchez, R.; Gómez-Sánchez, M.A. Efficiency of garden waste compost teas on potato growth and its suppressiveness against Rhizoctonia. Agric. For. 2018, 64, 7–14. [Google Scholar]
- Ezziyyani, M.; Requena, M.E.; Pérez-Sánchez, C.; Candela, M.E. Efecto del sustrato y la temperatura en el control biológico de Phytophthora capsici en pimiento (Capsicum annuum L.). An. de Biol. 2005, 27, 119–126. [Google Scholar]
- Tateda, M.; Yoneda, D.; Sato, Y. Effects of Compost Tea Making from Differently Treated Compost on Plant Disease Control. J. Wetl. Res. 2007, 9, 91–98. [Google Scholar]
- Pane, C.; Piccolo, A.; Spaccini, R.; Celano, G.; Villecco, D.; Zaccardelli, M. Agricultural waste-based composts exhibiting suppressivity to diseases caused by the phytopathogenic soil-borne fungi Rhizoctonia solani and Sclerotinia minor. Appl. Soil Ecol. 2013, 65, 43–51. [Google Scholar] [CrossRef]
- Krause, M.S.; Madden, L.V.; Hoitink, H.A.J. Effect of potting mix microbial carrying capacity on biological control of Rhizoctonia damping-off of radish and Rhizoctonia crown and root rot of poinsettia. Phytopathology 2001, 91, 1116–1123. [Google Scholar] [CrossRef] [PubMed] [Green Version]
- United Nations (UN). The 17 Goals. Department of Economic and Social Affairs. 2021. Available online: https://sdgs.un.org/goals (accessed on 8 February 2021).

| pH | EC (dS/m) | C/N | NO3− (ppm) | P2O5 (ppm) | K2O (ppm) | SO42− (ppm) | Ca2+ (ppm) | Mg2+ (ppm) | Humic Acids (mg/L) |
|---|---|---|---|---|---|---|---|---|---|
| 7.16 ± 0.15 | 1.2 ± 0.14 | 7.1 ± 0.2 | 2240.4 ± 225 | 61.4 ± 25 | 2851.2 ± 188 | 43 ± 20 | 280 ± 17 | 20 ± 14 | 198 ± 31 |
| Pathogen | RGR (%) |
|---|---|
| Rhizoctonia solani | 38.0 ± 4.2 |
| Phytophthora capsici | 31.7 ± 4.6 |
| Treatments | Days to Flowering (after Transplanting) | Plant Height (cm) | Stem Diameter (mm) | Chlorophyll Content (SPAD Units) |
|---|---|---|---|---|
| T1 | 40.1 a | 31.2 abc | 8.97 a | 37.6 a |
| T2 | 39.2 a | 33.0 ab | 7.72 bc | 40.9 a |
| T3 | 39.7 a | 31.0 abc | 9.10 a | 38.7 a |
| T4 | 48.6 b | 26.5 c | 7.80 bc | 37.1 a |
| T5 | 49.0 b | 30.0 bc | 7.65 c | 39.4 a |
| T6 | 40.1 a | 30.7 abc | 9.22 a | 39.2 a |
| T7 | 41.0 a | 36.2 a | 8.92 a | 38.5 a |
| T8 | 48.2 b | 33.5 ab | 8.60 ab | 41.6 a |
| T9 | 48.7 b | 33.2 ab | 8.40 abc | 38.6 a |
| T10 | 49.2 b | 29.7 bc | 7.92 bc | 39.8 a |
| Treatments | Total Fruit Number | Total Fruit Weight (g) | Mean of Fruit Weight (g) | Root Dry Weight (g) | Shoot Dry Weight (g) | Pathogen Incidence |
|---|---|---|---|---|---|---|
| T1 | 5 | 322.19 | 64.44 a | 8.71 ab | 5.25 b | 0 |
| T2 | 6 | 219.25 | 36.54 bc | 7.82 b | 5.59 b | 0 |
| T3 | 6 | 249.58 | 41.60 b | 8.94 ab | 6.07 ab | 0 |
| T4 | 4 | 171.21 | 42.80 b | 4.33 c | 4.01 c | 2 |
| T5 | 7 | 154.44 | 22.06 d | 3.70 cd | 3.55 c | 3 |
| T6 | 4 | 182.07 | 45.52 b | 11.60 a | 5.98 ab | 0 |
| T7 | 5 | 228.38 | 45.68 b | 10.59 a | 6.42 a | 0 |
| T8 | 7 | 209.38 | 29.91 c | 6.51 bc | 4.98 b | 1 |
| T9 | 4 | 147.13 | 36.78 bc | 4.98 c | 4.55 bc | 2 |
| T10 | 6 | 162.23 | 27.04 c | 8.66 ab | 4.95 b | 0 |
Publisher’s Note: MDPI stays neutral with regard to jurisdictional claims in published maps and institutional affiliations. |
© 2021 by the authors. Licensee MDPI, Basel, Switzerland. This article is an open access article distributed under the terms and conditions of the Creative Commons Attribution (CC BY) license (https://creativecommons.org/licenses/by/4.0/).
Share and Cite
González-Hernández, A.I.; Suárez-Fernández, M.B.; Pérez-Sánchez, R.; Gómez-Sánchez, M.Á.; Morales-Corts, M.R. Compost Tea Induces Growth and Resistance against Rhizoctonia solani and Phytophthora capsici in Pepper. Agronomy 2021, 11, 781. https://doi.org/10.3390/agronomy11040781
González-Hernández AI, Suárez-Fernández MB, Pérez-Sánchez R, Gómez-Sánchez MÁ, Morales-Corts MR. Compost Tea Induces Growth and Resistance against Rhizoctonia solani and Phytophthora capsici in Pepper. Agronomy. 2021; 11(4):781. https://doi.org/10.3390/agronomy11040781
Chicago/Turabian StyleGonzález-Hernández, Ana Isabel, M. Belén Suárez-Fernández, Rodrigo Pérez-Sánchez, María Ángeles Gómez-Sánchez, and María Remedios Morales-Corts. 2021. "Compost Tea Induces Growth and Resistance against Rhizoctonia solani and Phytophthora capsici in Pepper" Agronomy 11, no. 4: 781. https://doi.org/10.3390/agronomy11040781
APA StyleGonzález-Hernández, A. I., Suárez-Fernández, M. B., Pérez-Sánchez, R., Gómez-Sánchez, M. Á., & Morales-Corts, M. R. (2021). Compost Tea Induces Growth and Resistance against Rhizoctonia solani and Phytophthora capsici in Pepper. Agronomy, 11(4), 781. https://doi.org/10.3390/agronomy11040781






